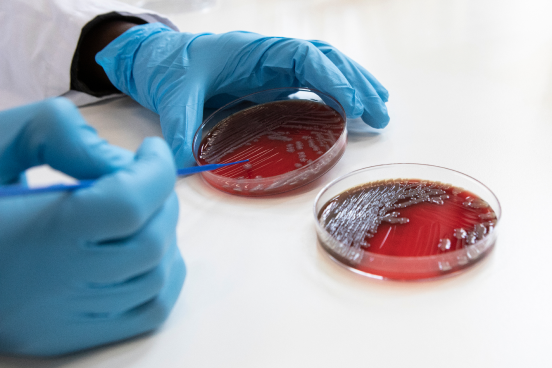

In spring 2022, an outbreak of mpox (formerly monkeypox) took the world by surprise, causing more than 85,000 infections worldwide, especially among men who have sex with men. Mpox is caused by the mpox virus, of which two types are known. Clade I has been most frequent and has caused several outbreaks in Central Africa, especially in the DRC. Clade II, on the other hand, occurs mainly in West Africa and causes a less severe disease than clade I. The 2022 global outbreak was caused by clade II and was the first time mpox has spread widely outside of Central and West Africa.
Field performance of three Ebola rapid diagnostic tests used during the 2018–20 outbreak in the eastern Democratic Republic of the Congo: a retrospective, multicentre observational study
Authors: Daniel Mukadi-Bamuleka et al.

In many African countries, the number of children being born in health facilities is increasing, but without corresponding improvements in the quality of care. The result is that more maternal deaths are attributable to poor quality of care than to the lack of access to care. Analysing data from recent Demographic Health Surveys, ITM researchers and African partners examined how nearly 20,000 women living in 22 large African cities used maternal care services. Cotonou in Benin and Accra in Ghana scored best: here most women were able to access health care facilities and reported receiving timely care. Most cities, however, showed inconsistent levels of accessibility and quality of care across the maternal continuum of care. The proposed typology of best- and worst-performing cities can provide a starting point for extracting lessons learnt and addressing critical gaps in maternal health in rapidly urbanising contexts.
Wong et al. A tale of 22 cities: utilisation patterns and content of maternal care in large African cities, BMJ Global Health, 2022
Wong et al., A tale of 22 cities: utilisation patterns and content of maternal care in large African cities, BMJ Global Health, 2022
Doubt at the core: Unspoken vaccine hesitancy among healthcare workers
Authors: Leonardo W Heyerdahl et al.

Malaria is a mosquito-borne infectious disease caused by the Plasmodium parasite that kills more than half a million people every year. Understanding the sexual conversion of the parasite is essential to interrupt transmission. The IMMETASEX research project (host immune and metabolic determinants of sexual conversion in Plasmodium parasites) hypothesises that immune and metabolite factors that are altered during malaria infection induce sexual conversion in Plasmodium falciparum parasites, the deadliest species of Plasmodium.
In this project, the researchers will develop a new tool to estimate sexual conversion rates providing essential knowledge on the factors that affect sexual conversion in the host. This will potentially inform novel strategies to interrupt transmission. Partner institutions of the study include the Barcelona Institute for Global Health and Leiden University Medical Centre. The clinical studies will be conducted in Burkina Faso and in Mozambique. The project is funded by the Research Foundation Flanders.
Four layer multi-omics reveals molecular responses to aneuploidy in Leishmania
Authors: Bart Cuypers et al.

Multidrug-resistant TB (MDR-TB) is caused by tuberculosis (TB) bacteria resistant to at least isoniazid and rifampicin, the two most potent TB drugs. In STREAM Stage 2, the first large-scale, multi-country phase III clinical trial of shortened treatment regimens for MDR-TB, a 9-month all oral regimen containing bedaquiline and a 6-month regimen containing injectable and bedaquiline, and both containing a 4th generation fluoroquinolone, were found to be safe and effective. Primary outcome results provide high-quality evidence that support the current WHO recommendation of 9-month, all oral bedaquiline-containing regimens for drug-resistant TB.
Bacteriophage-antibiotic combination therapy against extensively drug-resistant Pseudomonas aeruginosa infection to allow liver transplantation in a toddler
Authors: Brieuc Van Nieuwenhuyse et al.

For more than 10 years, our institute has been actively monitoring exotic mosquitoes in Belgium. ITM and the Belgian public health institute Sciensano have successfully counted on the help of citizens to report tiger mosquitoes via the new website MuggenSurveillance.be. The citizen science project, part of the MEMO+ project, resulted in multiple finds on nine locations. The project was funded by the federal and regional governments through the National Environmental Health Action Plan (NEHAP).
The ITM entomologists did not only find tiger mosquitoes but unexpectedly found the Asian bush mosquito as well. Its presence is an indication of the increasing introduction of exotic mosquitoes in Belgium. In Nepal, ITM studies the interaction between climate change, vector-borne diseases and health through the CLIMB project. As part of the DGD programme, ITM will be working closely together with the BP Koirala Institute of Health Sciences (BPKIHS) and the Nepal Health Research Council (NHRC) to collect information on the spread of vectors and pathogens, pilot new surveillance strategies, and formulate measures.
Three doses of BNT162b2 vaccine confer neutralising antibody capacity against the SARS-CoV-2 Omicron variant
Authors: Kevin Ariën et al.

The nexus between HIV and migration is gaining attention. Migration to the EU could increase by up to 44% between now and 2030 due to conflict, poverty and climate change. Researchers from ITM’s Sexual and Reproductive Health (SRH) Research Group worked with UNAIDS on a review to assess the level to which HIV affects migrants and what their access to the HIV care continuum is. The findings show that HIV is more prevalent among migrants living in precarious circumstances. They experience multiple barriers in accessing HIV prevention and care: migration and health policies, the health system, the community and on the individual level. To end AIDS by 2030, it is crucial to ensure equitable access to health services, regardless of immigration status, and to implement stigma-reducing interventions.
Nostlinger et al., HIV among migrants in precarious circumstances in the EU and European Economic Area, The Lancet HIV, 2022
The impact of COVID-19 on the provision of respectful maternity care: Findings from a global survey of health workers
Authors: Anteneh Asefa et al.

The island of Anjouan in Comoros, an archipelago in the Indian Ocean, has an annual incidence of 7.4 leprosy cases per 10,000 inhabitants – 24 times higher than the global average. As a follow-up to the PEOPLE study, which examined the effect of preventive measures in 110,000 people, ITM, Damien Foundation and Janssen Pharmaceutica started the BE-PEOPLE study in 2022.
In this new study, the combination of bedaquiline with rifampicin is tested as prophylaxis for leprosy among contacts of leprosy patients. Currently, bedaquiline is successfully used to treat multidrug-resistant tuberculosis. Since the bacilli causing leprosy and tuberculosis are closely related, using bedaquiline to prevent leprosy in patients might prove useful. In a safety trial, 310 persons were randomised to either rifampicin or rifampicin plus bedaquiline, and no major toxicity concerns have emerged. In the next phase, we will test the two prophylactic regimens on a population of 120,000 and compare the leprosy incidence.
The study is led by ITM and Damien Foundation and its partner, the National Leprosy and Tuberculosis Control Programme in the Comoros, and funded by Janssen Pharmaceutica, who also generously provide the study compound bedaquiline. Other partners include Leiden University Medical Center and the Netherlands Heart Institute in Amsterdam.
Braet, S. Investigating drug resistance of Mycobacterium leprae in the Comoros: an observational deep-sequencing study. The Lancet Microbe, 2022.
Relative contribution of low-density and asymptomatic infections to Plasmodium vivax transmission in the Amazon: pooled analysis of individual participant data from population-based cross-sectional surveys
Authors: Marcelo U Ferreira et al.
Bloodstream infections (BSI) are an important concern for public health. In low-resource settings (LRS), they account for more deaths than malaria. Starting appropriate antibiotic treatment early is pivotal for patient outcomes. The current standard for detecting BSI is a multi-day process. Private companies have ameliorated and shortened this process by developing blood culture automates and improved formulas for their blood culture bottles.
However, these are expensive, difficult to maintain and often not available in LRS. In an FWO-funded project, researchers from ITM’s Unit of Tropical Bacteriology examined the composition of commercial blood culture bottles and have evaluated a range of commonly used growth-promoting additives for their effect on bacterial growth. Their findings showed that a very simple blood culture broth supported the growth of the most common pathogens. This information is key to the design of a ready-to-use formulation that can be locally produced and will allow LRS laboratories to implement better and faster diagnosis of BSI.
Global burden of bacterial antimicrobial resistance in 2019: a systematic analysis
Authors: Christopher J L Murray et al.


In collaboration with the Flemish broadcaster VRT NWS and other partners, ITM launched two new EDUboxes, educational packages for secondary school pupils, in 2022.
The first one focuses on science for sustainable relationships between humans, animals and the planet. Climate change, urbanisation, globalisation and deforestation are throwing the earth out of balance. Exotic mosquitoes and fungi are also suddenly appearing in our regions. What impact do these phenomena have on the health of humans, animals and the planet?
The second EDUbox introduces students to different health systems around the world; they learn that every person has the right to good health, how governments ensure this, that inequalities persist and how epidemics can put pressure on the entire system.
By means of educational packages that can be used by secondary school teachers, ITM is increasing youth awareness of the institute’s and its partners’ research topics, encouraging them to think critically about the interconnections between global and local challenges.
On 14 September, the annual award ceremony of the Prize for Global Research took place. The prize is awarded yearly by the Province of Antwerp to Master after Master students of the University of Antwerp, the Institute of Development Policy and ITM. Through this award, the provincial government wants to stimulate promising graduation projects on global themes relating to resource-constrained settings.
Four former master’s students of ITM, graduates of the MSc in Public Health, MSc in Tropical Medicine and MSc in Tropical Animal Health, were among the 2022 winners. The prize serves as an important recognition of their hard work and a stimulus to pursue their fields of expertise. The four winning ITM graduates were Claire Julie Akwongo (Uganda), Joseph Bahati Djoki (DRC), Amber Hadermann (Belgium) and Calvin Tonga (Cameroon).


In 2021, the Prof Jozef Vandepitte Prize of the association of the Development Aid Doctors & Pharmacists Alumni of KU Leuven was awarded to Dr Marjan Pirard, Education Coordinator of ITM’s Department of Public Health. The prize is awarded every two years to stimulate sustainable educational projects in low-income countries. Dr Pirard received the award for her key role in ITM’s MSc in Public Health (MPH).
Every year, about 40 students enrol in the MPH programme, of which most come from low- and middle-income countries. Since she started heading the Education Unit of the Department of Public Health in 2012, Marjan has supported students and ensured that the programme remains of high quality and relevant in an ever-changing world. "The prize and the heart-warming reactions I received from ITM alumni and staff inspire me in my future work. It is also a recognition of the collective effort of colleagues in our MPH programme,” Marjan said.





















For decades, ITM has been housing a tiny ‘factory’ producing millions of tests every year for the screening and diagnosis of neglected tropical diseases (NTDs): human African trypanosomiasis (HAT) and visceral leishmaniasis, which affect humans, and surra, which occurs in animals like horses and dogs. Early detection is key to combat these diseases. The CATT test (short for Card Agglutination Trypanosomiasis Test), developed by ITM at the end of the 1970s, grew to become one of the most used field tests for detecting HAT or sleeping sickness on a large scale in West and Central Africa. To this day, ITM’s Unit of Applied Technology and Production develops it in-house. Annually, the portfolio now also contains 100,000 DAT/VL tests, used for the diagnosis of visceral leishmaniasis, and 120,000 surra tests, which are sold to veterinary hospitals around the world.
In 2022, the unit concentrated on improving and facilitating some important processes, such as client administration, production planning and stock management. To this end, they put in place a cloud-based ERP (Enterprise Resource Planning)/MRP (Manufacturing Resource Planning) software, suited for small manufacturers. Preparations also began for the setting up of a biobank, with human and non-human biological materials used for research. This will also be accessible to external applicants such as researchers from academic and non-academic origins or from commercial and non-profit organisations.

ITM laboratories are highly regarded as scientific centres of reference on tropical diseases, both nationally and internationally. They also work to improve services for patient care locally. In our high-security biosafety level 3+ (BSL-3+) labs we have the infrastructure to safely research dangerous pathogens such as tuberculosis and the Ebola virus.
Several of our research and diagnostic laboratories are recognised as reference laboratories by national governments and various international organisations such as the World Health Organization. As such, ITM’s laboratories are of the highest quality standards and our scientists are often called upon as expert advisors locally and worldwide.
